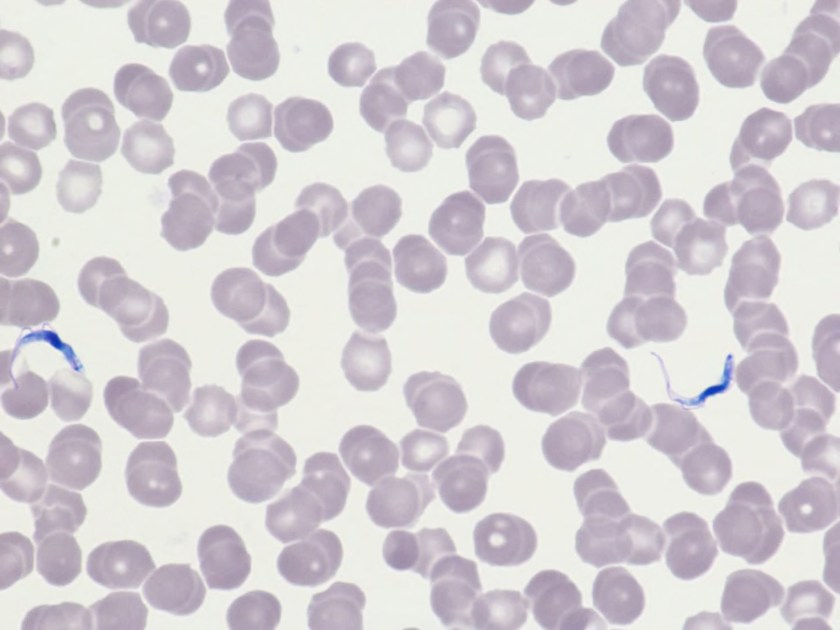
tryp1

Case History
A 68 year old man with no significant past medical history presented with 3 weeks of upper back pain and bilateral leg weakness. He denied numbness, tingling, leg pain or urinary or fecal incontinence. MRI showed severe cord compression at the upper thoracic spine with a T2-T5 epidural mass. Due to the patient’s decline, an urgent decompression was scheduled and the patient underwent T2-T5 thoracic laminectamies with resection of extramedullary epidural tumor.



Imaging
Frozen Section Diagnosis
“Round blue cell tumor. Await permanents for final diagnosis.”
Differential Diagnosis
Small round blue cell tumor is a term generally used for a group of neoplasms characterized by small, round, basophilic, relatively undifferentiated cells on H & E staining. The differential diagnosis is wide, but includes Ewing’s sarcoma/peripheral neuroectodermal tumor, mesenchymal chondrosarcoma, small cell osteosarcoma, desmoplastic small round cell tumor and Non-Hodgkin Lymphoma. 1

H&E, 2x







Diagnosis
Sections show fragments of fibrous tissue and focal bone with extensive crush artifact. There is an abnormal lymphoid infiltrate with areas showing a vaguely nodular architecture. The lymphocytes are small to medium in size with irregular cleaved nuclei, inconspicuous nucleoli and small amounts of cytoplasm. Scattered centroblastic cells are seen but are <15 per high power field. Between the nodules, the cells are centrocytic appearing. Rare mitotic figures are identified.
By immunohistochemistry, the neoplastic cells are immunoreactive for CD20 and BCL2. BCL2 is brighter in the vague nodular areas which are also highlighted by CD10 and BCL6. CD23 is variably positive in a large subset of cells. MUM1 is negative. CD21 highlights the enlarged and irregularly shaped follicular dendritic cell meshwork present in the areas with nodules. CD3 and CD5 highlights admixed T-cells. The proliferation index by Ki-67 is low and approximately 10%.
Cytogenetic analysis using fluorescent in-situ hybridization performed on paraffin embedded sections revealed numerous cells with an IGH/BCL double fusion probe signal pattern consistent with IGH/BCL2 gene rearrangement.
Overall, the morphologic and immunophenotyipic findings in conjunction with the cytogenetic results are in keeping with involvement by a B-cell lymphoma most consistent with a follicular lymphoma. The follicles present contain <15 centroblasts per hpf and the low proliferation fraction makes it most compatible with a low grade (WHO morphologic grade 1-2/3) follicular lymphoma.
Discussion
The differential diagnosis for an extramedullary epidural tumor is wide and can include anything from an epidural abscess to a metastasis. Although rare, lymphoma must be considered, especially when initial pathology shows “Round blue cells.”
Making the diagnosis of follicular lymphoma involves assessing the H & E slides for follicular architecture, characteristic immunostains including positivity for BCL2 within follicles and the typical t(14;18) IGH/BCL2 translocation, which occurs in 90% of cases. 2
Primary spinal epidural lymphoma (PSEL) includes extramedullary/extranodal lymphomas of the epidural space for which there are no other sites of disease at the time of diagnosis. As demonstrated in Figure 1 below, the lymphoma is seen entirely within the epidural space. 3

An epidural location for lymphoma is observed in 0.1-6.5% of cases. Patients tend to present in the fifth to seventh decade of life with a higher proportion of male to female cases. Presenting symptoms include weakness in the upper or lower limbs and back pain corresponding to the site of involvement of tumor. The most common tumor site is the thoracic spine (75%) followed by lumbar and cervical. Most epidural spinal tumors are B-cell lymphomas of intermediate and high grade, but low grade lymphomas have been reported. 3
Although rare, lymphoma is an important consideration in the differential diagnosis for tumors involving the spine. Surgical intervention is often necessary to relieve spinal cord compression and to make a histologic diagnosis. Treatment includes radiation and chemotherapy. Patients with primary spinal epidural lymphoma tend to have a better prognosis than patients with systemic lymphoma involving the epidural space, as well as patients with metastatic carcinoma. 3
References
- Hameed, Meera: Small Round Cell Tumors of Bone. Arch Pathol Lab Med (2007) 131: 192-204.
- Louis D.N., Ohgaki H., Wiestler O.D., Cavenee W.K. (Eds.): WHO Classification of Tumors of the Central Nervous System. IARC: Lyon 2007.
- Cugati G, Singh M, Pande A, et al. Primary spinal epidural lymphomas. Journal of Craniovertebral Junction and Spine (2011) 2(1): 3-11.

–Chelsea Marcus, MD is a third year resident in anatomic and clinical pathology at Beth Israel Deaconess Medical Center in Boston, MA and will be starting her fellowship in Hematopathology at BIDMC in July. She has a particular interest in High-grade B-Cell lymphomas and the genetic alterations of these lymphomas.